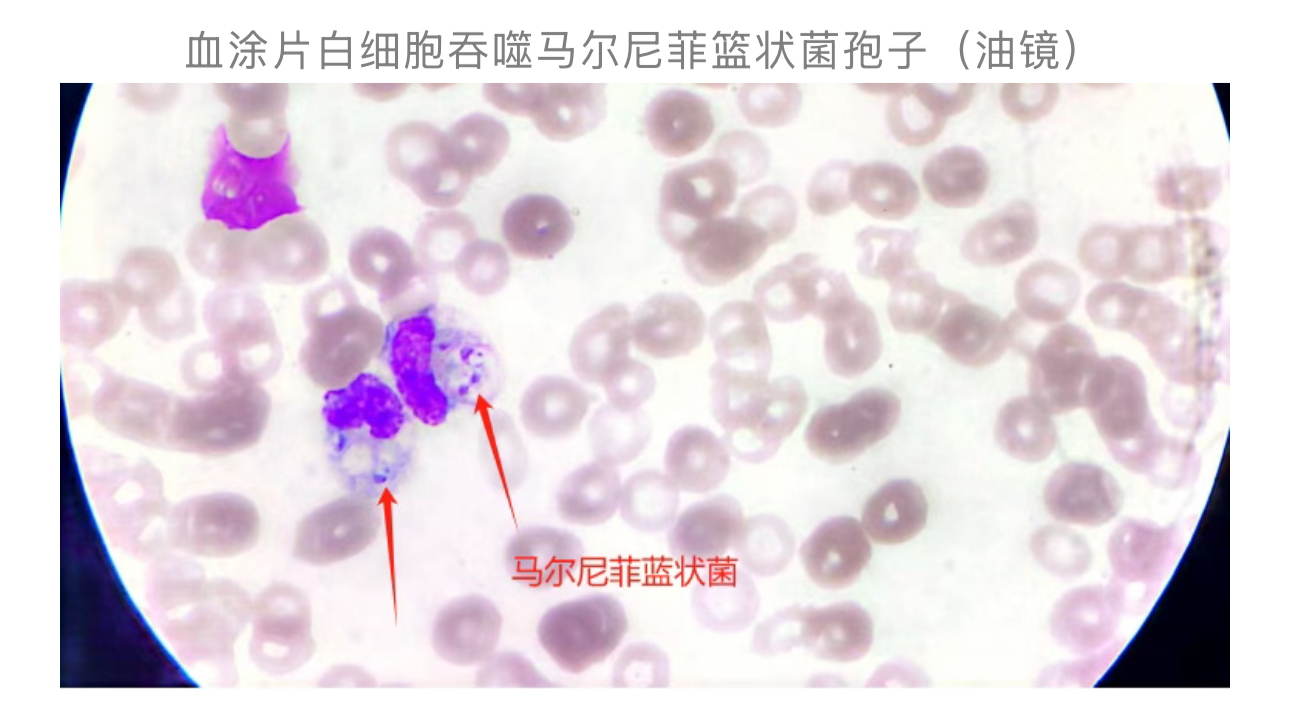
1761014655892354.jpg 1761014655892354.jpg

“一匹马”致患者死亡!警惕,免疫脆弱者的真菌感染生死劫
作者:凌军招
篮状菌病(talaromycosis)是一种由马尔尼菲篮状菌
(Talaromyces marneffei, TM)感染引发的侵袭性真菌病,我国通常称为马尔尼菲篮状菌病或马尔尼菲青霉菌病[1]。
该病主要患者为免疫功能低下人群,是一种地方性条件致病菌感染疾病,广泛流行于东南亚地区和我国广西、广东为主的华南地区[2]。
本文介绍一例由马尔尼菲篮状菌感染继发多脏器功能衰竭导致患者死亡的抢救案例,并结合《艾滋病
合并马尔尼菲篮状菌病诊疗专家共识(2024年更新版)》进行文献复习,旨在为临床和检验工作者提供相关诊断与治疗的参考。
案例经过及分析
患者男,64岁,当地人,无旅居史。
现病史
患者因不明原因发热
(最高 40.0℃)于7月7日-11日就诊外院,诊断为:肺部感染、消化道出血
、胸腹水、低蛋白血症、肝脾大
。11日晚,患者因急性呼吸衰竭
、感染性休克
转入ICU治疗;12日,因病情严重,患者家属放弃治疗并要求转院;12日16时,患者转入我院ICU治疗。
入院检查
体温 39.9℃、脉搏
128次/分、呼吸 16次/分、血压 71/38mmHg,血氧饱和度测不出;昏迷状态,格拉斯哥昏迷评分 GCS评分3分(E1V1M1);患者平车入院,浅表淋巴结肿大,双下肢轻度水肿
,双侧瞳孔等大等圆,直径2.0mm,对光反射迟钝,各深浅反射消失。
入院诊断
真菌性败血症
、急性呼吸衰竭(Ⅰ型)、感染性休克、多脏器功能损伤。
入院治疗
给予哌拉西林他唑巴坦
钠(抗细菌)及氟康唑
(抗真菌)抗感染,氨溴索
化痰,泮托拉唑
护胃,谷胱甘肽
保护脏器功能,血管活性药升血压,维持水电解质酸碱平衡等对症支持治疗。
12日,患者血常规
显示血小板计数 9×109/L↓,凝血功能显示纤维蛋白原 0.8g/L↓,均是危急值,患者家属拒绝输血
及血制品。
实验室检查
血气分析提示酸碱度PH 7.3301↓、氧分压 93mmHg、二氧化碳分压 26.34mmHg↓。
其他检查结果如下:

7月14日,患者痰细菌培养鉴定检出肺炎
克雷伯菌;16日,患者血培养
细菌培养鉴定检出马尔尼菲篮状菌。患者细菌、真菌合并感染,引发感染性休克、败血症,进而继发多脏器功能衰竭,累及呼吸、循环、肝、肾、凝血系统及消化道(伴消化道出血),病情进展迅猛。最终患者因继发多脏器功能衰竭,经全力抢救无效死亡。
血培养检出马尔尼菲篮状菌为确诊该菌感染的金标准,实验室检查提示患者炎症指标、肝肾功能指标及心肌酶谱显著升高,同时存在凝血功能障碍、代谢性酸中毒等表现,上述异常与感染性休克及多脏器损伤直接相关。
文献复习
血清学检查
1,3-β-D葡聚糖(1,3-β-D-Glucan)是多种真菌细胞壁的主要组成成分,G试验(真菌1,3-β-D葡聚糖检测)对TM病在内的侵袭性真菌感染
具有一定诊断价值,但缺乏菌种特异性,且BDG水平正常不能排除TM感染。
血清半乳甘露聚糖(galactomannan, GM)检测对于艾滋病合并TM病的诊断亦具有一定参考价值。该方法简便快捷,但易与其他真菌(如曲霉菌等)发生交叉反应。我国学者研究发现,以0.5ug/L为GM试验阳性临界值时,诊断TM病的敏感性和特异性分别为55.6%-81.4%和77.3%-96.8%。
酵母期特异性单克隆抗体mAb-4D1和mAb-Mp1p应用于TM病诊断方面具有良好前景。
病原学检查
真菌培养
TM病的确诊依赖于病原学检查。对骨髓和淋巴结活检组织进行真菌培养是最敏感的诊断方法,其次是利用皮损
刮取物及血液进行真菌培养;粪便、尿液、脑脊液及关节液中也可培养分离出TM。
尽管血培养是临床上最常用的病原学检测手段,但TM多在疾病晚期才易发生广泛播散入血,因此其漏诊率可高达50%;痰培养
和皮肤活检的敏感性分别为34%和90%;骨髓或淋巴结活检组织培养敏感性高达100%。多种样本联合培养有助于提高检出率。
尽管真菌培养是临床上诊断TM病的“金标准”,但该方法耗时常需3-14天,难以进行早期确诊,尤其在无皮疹
患者中更易延误诊断。
分子生物学检测
基于聚合酶链式反应
PCR的核酸检测
方案对于TM病有较高的敏感性和特异性,尤其是巢式PCR,几乎能够100%扩增出TM的 DNA。
宏基因组二代测序 mNGS是近年发展起来的病原体诊断新技术,用于TM病病原学诊断的敏感性和特异度可达100%和98.71%,且耗时短,但采样要求及检测成本较高,部分地区可及性差,可作为辅助诊断方法。
总结
非HIV感染合并马尔尼菲篮状菌感染的临床症状和实验室检查缺少特异性,容易发生误诊和漏诊;对于可疑病例,积极获取体液和组织样本进行培养和mNGS检测能够提高诊断率[2]。
提高对TM感染的警惕性:TM病好发于免疫功能低下人群(如艾滋病、长期使用激素 / 免疫抑制剂、恶性肿瘤等)及华南、东南亚流行地区患者,此类人群出现 “不明原因发热+多脏器损伤(肝脾大、皮疹、淋巴结肿大等)”,需优先考虑TM感染可能,尽早启动针对性检验。
TM病的早期诊断依赖 “临床警惕 + 合理检验策略”。检验科应发挥 “桥梁” 作用,通过精准检测为临床提供及时、可靠的诊断依据,从而降低漏诊率及死亡率[1],主动与临床沟通,提示“TM培养的特殊要求”“mNGS的采样注意事项”,对于有皮疹、溃疡的患者,在取分泌物培养时,最好请外科或皮肤科协助,消毒后切开溃疡或皮疹皮肤取脓性分泌物培养,提高检出率;临床需结合检验结果和药敏结果动态调整治疗。
专家点评
曾煌星 副主任技师
本文报告了一例由TM感染引发败血症并导致多脏器功能衰竭的死亡病例,具有重要的临床警示意义。该患者的诊疗过程反映了马尔尼菲篮状菌感染的凶险性,尤其是在免疫功能低下人群中的高致死率。在临床工作中,需重视多学科协作、早期诊断和精准检验。
参考文献:
[1] 艾滋病合并马尔尼菲篮状菌病诊疗专家共识(2024年更新版)[J].中国艾滋病性病,2024,30(06):563-572.DOI:10.13419/j.cnki.aids.2024.06.02.
[2] 沈凌,梁荣章,张超. 24例非HIV感染的肺马尔尼菲篮状菌病临床特征分析[J]. 临床肺科杂志,2025,30(7):1034-1039. DOI:10.3969/j.issn.1009-6663.2025.07.012.
来源:检验医学网